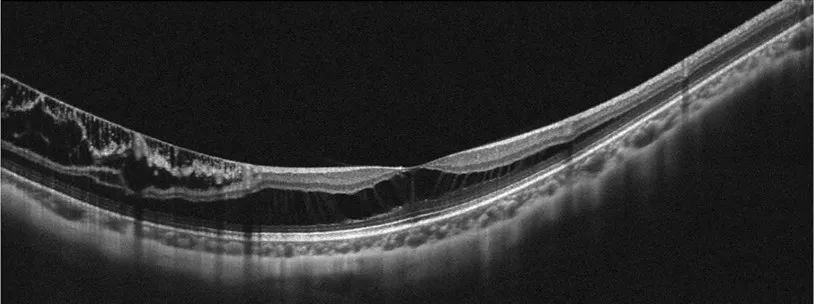

今年爱眼日的主题是
关注普遍的眼健康
对于中老年人来说
眼底疾病是特别需要关注的疾病之一
糖尿病视网膜病变
年龄相关性黄斑变性等
都是严重威胁
中老年人视觉健康的眼部疾病
而这些疾病通过眼底照相
就能做出较为明确的诊断
什么是眼底照
如果说眼球是一台照相机,那么眼底就是照相机的底片。

图片来源:网络
而眼底照就是给“眼睛的底片”拍照,可以观察到视网膜、视神经、黄斑、视网膜血管等结构的基本情况,从而帮助我们发现眼病的蛛丝马迹,某些情况下还可以初步判断全身的健康状态,具有无创、快捷、操作简单、结果即查即出等优点。
根据拍摄范围的不同,可以分为普通眼底彩照以及超广角激光扫描眼底照相(SLO)。


左:正常人左眼眼底彩照;右:正常人左眼超广角激光扫描眼底照
哪些人需要拍摄眼底照
高度近视
高度近视主要指近视度数≥600度的屈光不正状态,这类人群出现眼底病变的概率可达8.5%-24.3%。广角眼底照片可以拍到极周边的视网膜,让视网膜变性区、视网膜裂孔、视网膜脱离等情况无所遁形!

高度近视视网膜病变
老年人
黄斑是视网膜上最重要的正常结构,是人眼视力最敏感的区域。随着年龄的增长,当黄斑区出现病变时,会导致中心暗区、看东西扭曲变形、视物模糊等症状。眼底照可以看到黄斑区是否出现出血、渗出、玻璃体膜疣等表现,帮助我们早期发现黄斑区疾病并判断疾病的严重程度。

湿性年龄相关性黄斑变性
青光眼家族史
视神经在眼睛中起着“电线”的作用,可以把眼睛看到的图像传递到大脑,当视神经出现问题时可能出现视野缺损或视力下降等症状。最常见的视神经疾病就叫“青光眼”,眼底照可以直接观察到视神经,早期发现青光眼的视神经改变,提示我们尽早进行青光眼的排查。

眼底照发现杯盘比大的话,要尽早到眼科医院进行排除青光眼的相关检查
糖尿病
糖尿病视网膜病变是造成工作年龄段成年人不可逆视力损伤的首要原因,早期的糖尿病视网膜病变患者没有明显的症状,但是此时眼底可能已经出现微血管瘤、硬性渗出、棉絮斑、小出血点等表现,需要及时干预治疗,避免失明的风险。

糖尿病视网膜病变
除了眼底照相,现在我们还可以进行相干光断层扫描(OCT)对眼底进行检查,这样可以获取比眼底彩照更精确的视网膜断层图像,可以更早的对疾病进行诊断,特别是各种类型的黄斑病变,如黄斑裂孔、黄斑前膜、黄斑水肿等,OCT可以让各种病变无处遁形。
高度近视黄斑劈裂
OCT血管成像技术
近年来OCT血管成像技术也越来越成熟,一次扫描,可以观察到血管细微结构,几乎可以与传统血管造影相媲美,又避免了静脉穿刺以及造影剂过敏的风险,赢得了越来越多医生和患者的喜爱

视网膜静脉阻塞患者超广角OCT血管成像
AI辅助眼底疾病筛查
眼底病高发且致盲,但是目前我国具有资质进行眼底病筛查的眼科医生却处于严重短缺状态。随着科学技术的发展,人工智能(AI)技术在眼底病诊疗中也发挥着重要作用,可以对病理性近视、黄斑变性、糖尿病视网膜病变、动脉硬化等多种疾病进行判读与筛查。
北京协和医院也是眼科AI的早期探索者,不仅率先开展了眼底照相眼部多病种AI辅助诊断的临床试验,近年来也致力于基于眼底照相的AI对全身疾病的预测与识别以及在远程医疗中的应用等。

通过对眼底的尽早关注,可以及时发现眼部疾病甚至是全身疾病,从而做到早诊断、早治疗。为了大家的眼睛健康,定期的眼底筛查是非常有必要的!还等什么,赶紧约起来吧!




